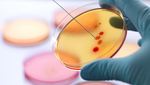

M&G Investments auf einen Blick:
- M&G Investments ist eine globale Fondsgesellschaft mit signifikanter Größe.
- M&G Investments bietet den Zugang zu einer Vielfalt von Kompetenzen. Dazu gehören Anleihen, Aktien, Multi-Asset, Immobilien, Private Credit, Infrastruktur und Private Equity.
- In Europa gehört M&G Investments zu den größten Verwaltern von Private Asset. Darüber hinaus ist die Fondsgesellschaft für seine weltweite Anleihen-und Aktien Expertise mit langjähriger Erfahrung bekannt.
M&G Investments ist Teil von M&G plc, einem internationalen Finanzdienstleister. Menschen dabei zu helfen, ihr Vermögen verantwortungsvoll zu verwalten und zu vermehren ist unser gemeinsames Ziel.
Weltweit verwalten wir über 394 Milliarden Euro (per 31. Dezember 2025) im Auftrag von privaten und professionellen Anlegern, darunter Banken, Pensionsfonds, Versicherungen, Staatsfonds, Family Offices und Berater.
Wir sind einer der größten Verwalter von Private Assets in Europa. Darüber hinaus sind wir für unsere weltweite Anleihen-Expertise, unsere langjährige Erfahrung bei Multi-Asset-Lösungen und unsere Innovationskraft im Aktienbereich bekannt. Dazu gehört auch ein wachsendes Angebot an thematischen Aktienfonds, die auf Nachhaltigkeit ausgerichtet sind. Dank dieser Größe verfügen wir über einen einzigartigen Zugang zu börsennotierten Anlagemöglichkeiten und zu Private Markets. Unseren Kunden bieten wir ein breites Spektrum an Fonds und maßgeschneiderten Lösungen.
Der Wert eines Investments kann sowohl fallen als auch steigen. Dies führt dazu, dass Preise steigen und fallen können, und Sie bekommen möglicherweise weniger zurück, als Sie ursprünglich investiert haben. Die frühere Wertentwicklung stellt keinen Hinweis auf die künftige Wertentwicklung dar.
Weitere Informationen
- HomepageMehrwert durch Value InvestingExperten für asiatische AktienMit globalen Aktien laufende Erträge erzielenWebcasts
Kontakt
M&G Luxembourg S.A.
Niederlassung Deutschland
Taunusanlage 19
60325 Frankfurt am Main
Tel.: +49 69 1338 6720
info@mandg.de
Ansprechpartner



Soziale Netzwerke
Newsletter
AnmeldungWebinare

15 Minutes – Was die Märkte bewegt
Ivan Domjanic, unser Spezialist für Marktupdates bei M&G Investments, lädt Sie an jedem ersten Mittwoch im Monat um 9:30 Uhr zu unserer beliebten Webcast-Serie Fifteen Minutes ein. Durch seine ...
Podcast Episoden

Krieg am Golf: Kommt das dicke Ende für die Börsen erst noch?
Wenngleich die Kapitalmärkte im Zuge des Krieges am Persischen Golf immer wieder stark schwanken, haben die Anleger bisher mehrheitlich vergleichsweise gelassen reagiert. Ist dieses Verhalten ...

Kapitalmärkte 2026: Neue Chancen, neue Spielregeln?
2025 hat viele Anleger überrascht: ein relativ schwacher US-Aktienmarkt, eine starke Gold-Rallye und Kapitalflüsse zurück nach Europa und Asien. Doch was lässt sich daraus für die strategische ...

Neue Kräfte im Markt: Asiens Dynamik, Amerikas Druck Neue Kräfte im Markt: Asiens Dynamik, Amerikas Druck
Asien rückt in den Vordergrund: Günstige Bewertungen, steigende Dividenden und Aktienrückkäufe machen die Märkte dort für Investoren immer attraktiver. Länder wie China und Südkorea erscheinen ...
Mediathek

Tanzen, solange die Musik spielt?
Der Bullenmarkt an den Aktienmärkten scheint ungebrochen - trotz hoher Bewertungen und Zollunsicherheiten. Allerdings steigt die Konzentration der großen Tech-Unternehmen in den amerikanischen Indizes ...

Markt³ | 1. Quartal 2026
„Same procedure as last year?“ – ,,Wohl nicht", meinen die geladenen Kapitalmarktexperten. In 2025 sorgte vor allem „der größte Betriebsunfall der amerikanischen Geschichte“ für Turbulenzen an den ...

Antizyklisches Investieren: Viele reden davon, aber wie geht es richtig?
„Im Einkauf liegt der Gewinn“, „Billig kaufen, teuer verkaufen“ oder „An der Börse sollst du geben, wenn andere nehmen wollen, und nehmen, wenn andere geben wollen“ - solche Sätze kennen wir zuhauf. ...